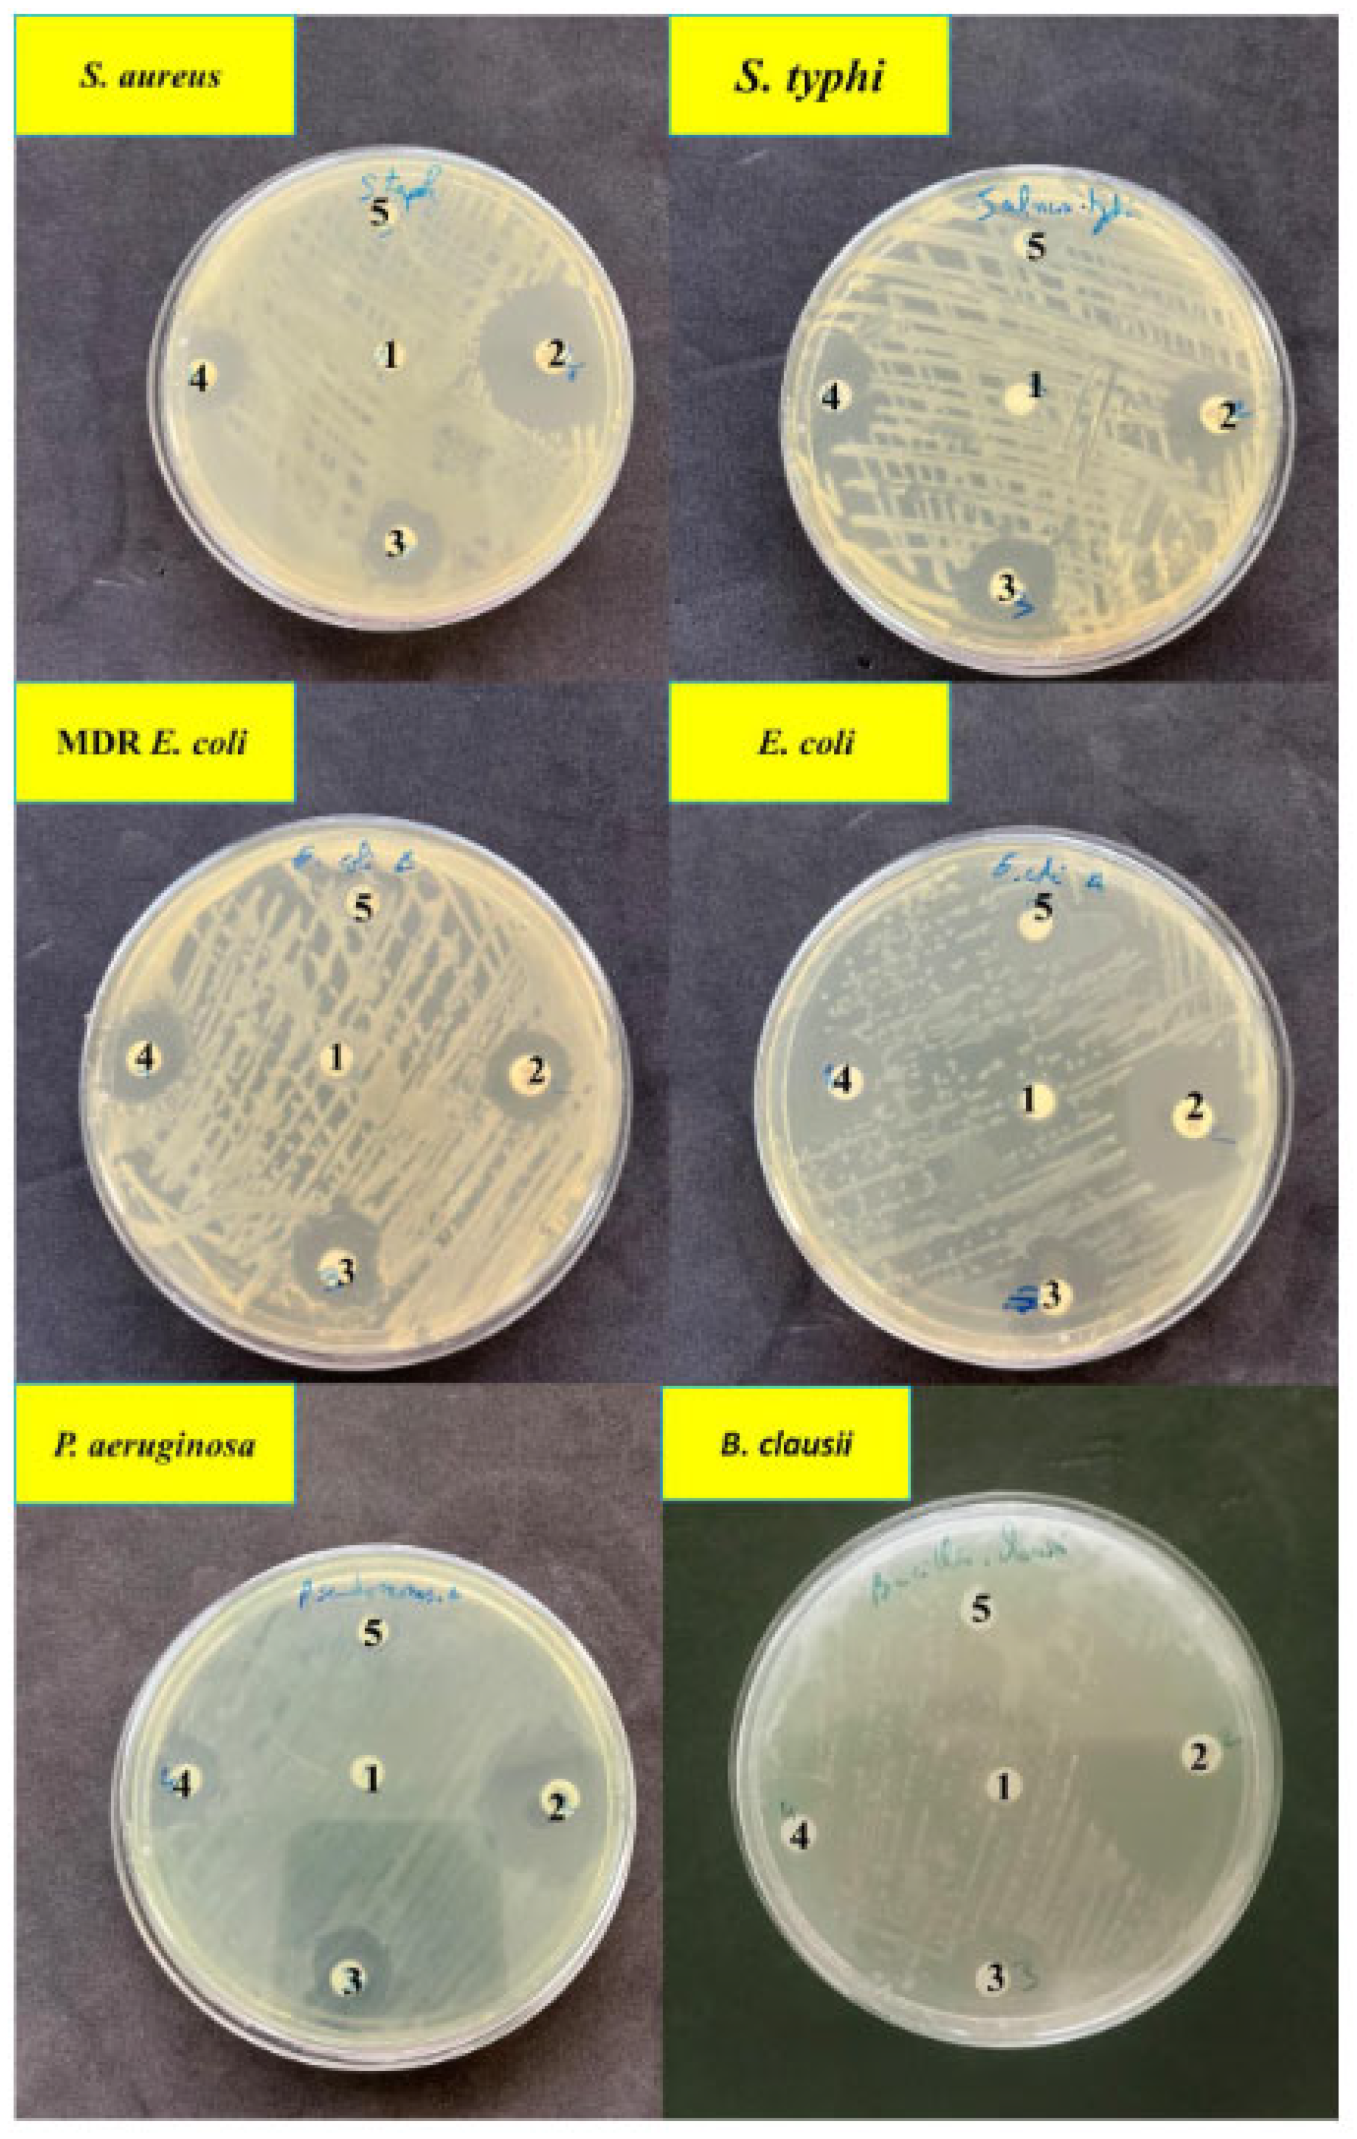
Ijms 24 10599 g007

Biosynthesis and Characterization of Silver Nanoparticles Produced by Parachlorella kessleri and Cyclotella spp., and the Evaluation of Their Antibacterial Activity
Abstract
1. Introduction
2. Results and Discussion
2.1. UV-Vis Spectroscopy of AgNPs
2.2. Characterization of AgNPs
2.3. Antibacterial Activity of AgNPs
3. Methods and Materials
3.1. Collection and Cultivation of Microalgae
3.2. Biosynthesis of Silver Nanoparticles
3.3. Characterization of AgNPs
3.4. Evaluation of the Antibacterial Efficacy of AgNPs
3.5. Statistical Analysis
4. Conclusions
Supplementary Materials
Author Contributions
Funding
Institutional Review Board Statement
Informed Consent Statement
Data Availability Statement
Conflicts of Interest
References
- Sharma, A.; Nagarajan, J.; Gopalakrishnan, K.; Bodana, V.; Singh, A.; Prabhakar, P.K.; Suhag, R.; Kumar, R. Chapter9—Nanotechnology Applications and Implications in Food Industry. In Nanotechnology Applications for Food Safety and Quality Monitoring; Sharma, A., Vijayakumar, P.S., Prabhakar, E.P.K., Kumar, R., Eds.; Academic Press: New York, NY, USA, 2023; pp. 171–182. ISBN 978-0-323-85791-8. [Google Scholar]
- Malik, S.; Muhammad, K.; Waheed, Y. Nanotechnology: A Revolution in Modern Industry. Molecules 2023, 28, 661. [Google Scholar] [CrossRef]
- Kumar, R.; Kumar, M.; Luthra, G. Fundamental Approaches and Applications of Nanotechnology: A Mini Review. Mater. Today Proc. 2023. [Google Scholar] [CrossRef]
- Bordiwala, R.V. Green Synthesis and Applications of Metal Nanoparticles—A Review Article. Results Chem. 2023, 5, 100832. [Google Scholar] [CrossRef]
- Sanchis-Gual, R.; Coronado-Puchau, M.; Mallah, T.; Coronado, E. Hybrid Nanostructures Based on Gold Nanoparticles and Functional Coordination Polymers: Chemistry, Physics and Applications in Biomedicine, Catalysis and Magnetism. Coord. Chem. Rev. 2023, 480, 215025. [Google Scholar] [CrossRef]
- Verma, J.; Warsame, C.; Seenivasagam, R.K.; Katiyar, N.K.; Aleem, E.; Goel, S. Nanoparticle-Mediated Cancer Cell Therapy: Basic Science to Clinical Applications. Cancer Metastasis Rev. 2023, 1–27. [Google Scholar] [CrossRef] [PubMed]
- Materials/Free Full-Text/Supplementation of Polymeric Reservoirs with Redox-Responsive Metallic Nanoparticles as a New Concept for the Smart Delivery of Insulin in Diabetes. Available online: https://www.mdpi.com/1996-1944/16/2/786 (accessed on 1 June 2023).
- Coatings/Free Full-Text/Bimetallic Assembled Silver Nanoparticles Impregnated in Aspergillus Fumigatus Extract Damage the Bacterial Membrane Surface and Release Cellular Contents. Available online: https://www.mdpi.com/2079-6412/12/10/1505 (accessed on 4 June 2023).
- Tran, M.-T.; Nguyen, L.-P.; Nguyen, D.-T.; Le Cam-Huong, T.; Dang, C.-H.; Chi, T.T.K.; Nguyen, T.-D. A Novel Approach Using Plant Embryos for Green Synthesis of Silver Nanoparticles as Antibacterial and Catalytic Agent. Res. Chem. Intermed. 2021, 47, 4613–4633. [Google Scholar] [CrossRef]
- Jamkhande, P.G.; Ghule, N.W.; Bamer, A.H.; Kalaskar, M.G. Metal Nanoparticles Synthesis: An Overview on Methods of Preparation, Advantages and Disadvantages, and Applications. J. Drug Deliv. Sci. Technol. 2019, 53, 101174. [Google Scholar] [CrossRef]
- Roy, P.; Das, B.; Mohanty, A.; Mohapatra, S. Green Synthesis of Silver Nanoparticles Using Azadirachta Indica Leaf Extract and Its Antimicrobial Study. Appl. Nanosci. 2017, 7, 843–850. [Google Scholar] [CrossRef]
- Jacob, J.M.; Ravindran, R.; Narayanan, M.; Samuel, S.M.; Pugazhendhi, A.; Kumar, G. Microalgae: A Prospective Low Cost Green Alternative for Nanoparticle Synthesis. Curr. Opin. Environ. Sci. Health 2021, 20, 100163. [Google Scholar] [CrossRef]
- El-Sheekh, M.M.; Hassan, L.H.S.; Morsi, H.H. Evaluation of Antimicrobial Activities of Blue-Green Algae-Mediated Silver and Gold Nanoparticles. Rend. Fis. Acc. Lincei 2021, 32, 747–759. [Google Scholar] [CrossRef]
- Hamed, S.M.; Mostafa, A.M.A.; Abdel-Raouf, N.; Ibraheem, I.B.M. Biosynthesis of Silver and Silver Chloride Nanoparticles by Parachlorella kessleri SAG 211-11 and Evaluation of Its Nematicidal Potential against the Root-Knot Nematode; Meloidogyne incognita. Aust. J. Basic Appl. Sci. 2016, 10, 354–364. [Google Scholar]
- Kadukova, J. Surface Sorption and Nanoparticle Production as a Silver Detoxification Mechanism of the Freshwater Alga Parachlorella kessleri. Bioresour. Technol. 2016, 216, 406–413. [Google Scholar] [CrossRef]
- Kashyap, M.; Samadhiya, K.; Ghosh, A.; Anand, V.M.; Shirage, P.; Bala, K. Screening of Microalgae for Biosynthesis and Optimization of Ag/AgCl Nano Hybrids Having Antibacterial Effect. RSC Adv. 2019, 9, 25583–25591. [Google Scholar] [CrossRef]
- Liaqat, N.; Jahan, N.; Khalil-ur-Rahman; Anwar, T.; Qureshi, H. Green Synthesized Silver Nanoparticles: Optimization, Characterization, Antimicrobial Activity, and Cytotoxicity Study by Hemolysis Assay. Front. Chem. 2022, 10, 952006. [Google Scholar] [CrossRef]
- Gurunathan, S.; Lee, K.-J.; Kalishwaralal, K.; Sheikpranbabu, S.; Vaidyanathan, R.; Eom, S.H. Antiangiogenic Properties of Silver Nanoparticles. Biomaterials 2009, 30, 6341–6350. [Google Scholar] [CrossRef]
- Hazaa, M.; Alm-Eldin, M.; Ibrahim, A.-E.; Elbarky, N.; Salama, M.; Sayed, R.; Sayed, W. Biosynthesis of Silver Nanoparticles Using Borago Officinslis Leaf Extract, Characterization and Larvicidal Activity against Cotton Leaf Worm, Spodoptera Littoralis (Bosid). Int. J. Trop. Insect Sci. 2021, 41, 145–156. [Google Scholar] [CrossRef]
- Chitra, K.; Annadurai, G. Antibacterial Activity of PH-Dependent Biosynthesized Silver Nanoparticles against Clinical Pathogen. BioMed Res. Int. 2014, 2014, e725165. [Google Scholar] [CrossRef]
- Yurtluk, T.; Akçay, F.A.; Avcı, A. Biosynthesis of Silver Nanoparticles Using Novel Bacillus Spp. SBT8. Prep. Biochem. Biotechnol. 2018, 48, 151–159. [Google Scholar] [CrossRef]
- Mora-Godínez, S.; Abril-Martínez, F.; Pacheco, A. Green Synthesis of Silver Nanoparticles Using Microalgae Acclimated to High CO2. Mater. Today Proc. 2022, 48, 5–9. [Google Scholar] [CrossRef]
- Bao, Z.; Lan, C.Q. Mechanism of Light-Dependent Biosynthesis of Silver Nanoparticles Mediated by Cell Extract of Neochloris Oleoabundans. Colloids Surf. B Biointerfaces 2018, 170, 251–257. [Google Scholar] [CrossRef]
- Ivanova-Tolpintseva, A.; Tynkevych, O.; Diaconu, A.; Rotaru, A.; Khalavka, Y. Synthesis and Light-Induced Aggregation of Benzoate-Stabilized Silver Nanoparticles. Appl. Nanosci. 2019, 9, 709–714. [Google Scholar] [CrossRef]
- Jena, J.; Pradhan, N.; Nayak, R.R.; Dash, B.P.; Sukla, L.B.; Panda, P.K.; Mishra, B.K. Microalga Scenedesmus Spp.: A Potential Low-Cost Green Machine for Silver Nanoparticle Synthesis. J. Microbiol. Biotechnol. 2014, 24, 522–533. [Google Scholar] [CrossRef] [PubMed]
- Arya, A.; Gupta, K.; Chundawat, T.S.; Vaya, D. Biogenic Synthesis of Copper and Silver Nanoparticles Using Green Alga Botryococcus braunii and Its Antimicrobial Activity. Bioinorg. Chem. Appl. 2018, 2018, 7879403. [Google Scholar] [CrossRef] [PubMed]
- Alahmad, A.; Feldhoff, A.; Bigall, N.C.; Rusch, P.; Scheper, T.; Walter, J.-G. Hypericum perforatum L.-Mediated Green Synthesis of Silver Nanoparticles Exhibiting Antioxidant and Anticancer Activities. Nanomaterials 2021, 11, 487. [Google Scholar] [CrossRef] [PubMed]
- Baran, M.F.; Keskin, C.; Baran, A.; Hatipoğlu, A.; Yildiztekin, M.; Küçükaydin, S.; Kurt, K.; Hoşgören, H.; Sarker, M.M.R.; Sufianov, A.; et al. Green Synthesis of Silver Nanoparticles from Allium Cepa L. Peel Extract, Their Antioxidant, Antipathogenic, and Anticholinesterase Activity. Molecules 2023, 28, 2310. [Google Scholar] [CrossRef]
- Aboelfetoh, E.F.; El-Shenody, R.A.; Ghobara, M.M. Eco-Friendly Synthesis of Silver Nanoparticles Using Green Algae (Caulerpa Serrulata): Reaction Optimization, Catalytic and Antibacterial Activities. Env. Monit. Assess. 2017, 189, 349. [Google Scholar] [CrossRef]
- Vanti, G.L.; Kurjogi, M.; Basavesha, K.N.; Teradal, N.L.; Masaphy, S.; Nargund, V.B. Synthesis and Antibacterial Activity of Solanum Torvum Mediated Silver Nanoparticle against Xxanthomonas Axonopodis Pv.Punicae and Ralstonia Solanacearum. J. Biotechnol. 2020, 309, 20–28. [Google Scholar] [CrossRef]
- Muthusamy, G.; Thangasamy, S.; Raja, M.; Chinnappan, S.; Kandasamy, S. Biosynthesis of Silver Nanoparticles from Spirulina Microalgae and Its Antibacterial Activity. Environ. Sci. Pollut. Res. 2017, 24, 19459–19464. [Google Scholar] [CrossRef]
- Rajeshkumar, S.; Kannan, C.; Annadurai, G. Synthesis and Characterization of Antimicrobial Silver Nanoparticles Using Marine Brown Seaweed Padina tetrastromatica. Drug Invent. Today 2012, 4, 511–513. [Google Scholar]
- Saxena, J.; Sharma, P.K.; Sharma, M.M.; Singh, A. Process Optimization for Green Synthesis of Silver Nanoparticles by Sclerotinia sclerotiorum MTCC 8785 and Evaluation of Its Antibacterial Properties. SpringerPlus 2016, 5, 861. [Google Scholar] [CrossRef]
- Gole, A.; Dash, C.; Ramakrishnan, V.; Sainkar, S.R.; Mandale, A.B.; Rao, M.; Sastry, M. Pepsin−Gold Colloid Conjugates: Preparation, Characterization, and Enzymatic Activity. Langmuir 2001, 17, 1674–1679. [Google Scholar] [CrossRef]
- Hamida, R.S.; Ali, M.A.; Almohawes, Z.N.; Alahdal, H.; Momenah, M.A.; Bin-Meferij, M.M. Green Synthesis of Hexagonal Silver Nanoparticles Using a Novel Microalgae Coelastrella Aeroterrestrica Strain BA_Chlo4 and Resulting Anticancer, Antibacterial, and Antioxidant Activities. Pharmaceutics 2022, 14, 2002. [Google Scholar] [CrossRef]
- Feng, Q.L.; Wu, J.; Chen, G.Q.; Cui, F.Z.; Kim, T.N.; Kim, J.O. A Mechanistic Study of the Antibacterial Effect of Silver Ions On Escherichia coli and Staphylococcus aureus. J. Biomed. Mater. Res. 2000, 52, 662–668. [Google Scholar] [CrossRef]
- Alotaibi, A.M.; Alsaleh, N.B.; Aljasham, A.T.; Tawfik, E.A.; Almutairi, M.M.; Assiri, M.A.; Alkholief, M.; Almutairi, M.M. Silver Nanoparticle-Based Combinations with Antimicrobial Agents against Antimicrobial-Resistant Clinical Isolates. Antibiotics 2022, 11, 1219. [Google Scholar] [CrossRef]
- Slavin, Y.N.; Asnis, J.; Häfeli, U.O.; Bach, H. Metal Nanoparticles: Understanding the Mechanisms behind Antibacterial Activity. J. Nanobiotechnol. 2017, 15, 65. [Google Scholar] [CrossRef]
- Gurunathan, S.; Han, J.W.; Kwon, D.-N.; Kim, J.-H. Enhanced Antibacterial and Anti-Biofilm Activities of Silver Nanoparticles against Gram-Negative and Gram-Positive Bacteria. Nanoscale Res. Lett. 2014, 9, 373. [Google Scholar] [CrossRef]
- Youssef, M.; Zahra, B.; Yassine, E.A.; Lhoucine, B. Investigation of Lipid Production and Fatty Acid Composition in Some Native Microalgae from Agadir Region in Morocco. Afr. J. Biotechnol. 2020, 19, 754–762. [Google Scholar] [CrossRef]
- Roy, S.; Das, T.K. Protein Capped Silver Nanoparticles from Fungus: X-ray Diffraction Studies with Antimicrobial Properties against Bacteria. Int. J. Chem. Tech. Res. 2015, 7, 1452–1459. [Google Scholar]
- Bauer, A.W.; Kirby, W.M.M.; Sherris, J.C.; Turck, M. Antibiotic Susceptibility Testing by a Standardized Single Disk Method. Am. J. Clin. Pathol. 1966, 45, 493–496. [Google Scholar] [CrossRef] [PubMed]
- Rautela, A.; Rani, J.; Debnath (Das), M. Green Synthesis of Silver Nanoparticles from Tectona grandis Seeds Extract: Characterization and Mechanism of Antimicrobial Action on Different Microorganisms. J. Anal. Sci. Technol. 2019, 10, 5. [Google Scholar] [CrossRef]

| The Tested Strains | AgNO3 | AgNPs (a) | AgNPs (b) | Gentamycin | ||
|---|---|---|---|---|---|---|
| IZ (mm) | IZ (mm) | MIC (µg/mL) | IZ (mm) | MIC (µg/mL) | IZ (mm) | |
| E. coli ATCC25922 | ND | 14.33 ± 0.57 b | 25 | 17.33 ± 1.15 bc | 25 | 16.00 ± 00 b |
| MDR E. coli | ND | 13.66 ± 0.57 a | 25 | 15.00 ± 0.00 a | 25 | 13.66 ± 0.57 a |
| P. aeruginosa ATCC27853 | ND | 16.66 ± 0.57 b | 25 | 15.33 ± 0.57 a | 25 | 23.33 ± 0.57 c |
| S. aureus ATCC29213 | ND | 13.66 ± 1.15 a | 50 | 16.66 ± 0.57 abc | 50 | 27.33 ± 0.57 d |
| B. clausii | ND | 20.66 ± 1.52 c | 50 | 21.33 ± 1.15 d | 50 | 34.66 ± 0.57 e |
| S. typhi | ND | 16.66 ± 1.15 b | 25 | 18.00 ± 1.00 c | 25 | 16.33 ± 0.57 b |
| Valeur p | p = 0.00 * | p = 0.00 * | p = 0.00 * | |||
Disclaimer/Publisher’s Note: The statements, opinions and data contained in all publications are solely those of the individual author(s) and contributor(s) and not of MDPI and/or the editor(s). MDPI and/or the editor(s) disclaim responsibility for any injury to people or property resulting from any ideas, methods, instructions or products referred to in the content. |
© 2023 by the authors. Licensee MDPI, Basel, Switzerland. This article is an open access article distributed under the terms and conditions of the Creative Commons Attribution (CC BY) license (https://creativecommons.org/licenses/by/4.0/).
Share and Cite
El Ouardy, K.; Lbouhmadi, R.; Attaoui, H.; Mouzaki, M.; Mouine, H.; Lemkhente, Z.; Mir, Y. Biosynthesis and Characterization of Silver Nanoparticles Produced by Parachlorella kessleri and Cyclotella spp., and the Evaluation of Their Antibacterial Activity. Int. J. Mol. Sci. 2023, 24, 10599. https://doi.org/10.3390/ijms241310599
El Ouardy K, Lbouhmadi R, Attaoui H, Mouzaki M, Mouine H, Lemkhente Z, Mir Y. Biosynthesis and Characterization of Silver Nanoparticles Produced by Parachlorella kessleri and Cyclotella spp., and the Evaluation of Their Antibacterial Activity. International Journal of Molecular Sciences. 2023; 24(13):10599. https://doi.org/10.3390/ijms241310599
Chicago/Turabian StyleEl Ouardy, Khadija, Rkia Lbouhmadi, Hind Attaoui, Mustapha Mouzaki, Hanane Mouine, Zohra Lemkhente, and Youssef Mir. 2023. "Biosynthesis and Characterization of Silver Nanoparticles Produced by Parachlorella kessleri and Cyclotella spp., and the Evaluation of Their Antibacterial Activity" International Journal of Molecular Sciences 24, no. 13: 10599. https://doi.org/10.3390/ijms241310599
APA StyleEl Ouardy, K., Lbouhmadi, R., Attaoui, H., Mouzaki, M., Mouine, H., Lemkhente, Z., & Mir, Y. (2023). Biosynthesis and Characterization of Silver Nanoparticles Produced by Parachlorella kessleri and Cyclotella spp., and the Evaluation of Their Antibacterial Activity. International Journal of Molecular Sciences, 24(13), 10599. https://doi.org/10.3390/ijms241310599

